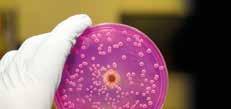

Alberto Sánchez Hernández Director General
Abdel Pérez Lorenzana Secretario Académico
Martha Espinosa Cantellano Secretaria de Planeación
Jesús Corona Uribe Secretario Administrativo
Ricardo Cerón Plata Subdirector de Intercambio Académico
Víctor Juárez Lomán Jefe del Departamento de Difusión
Revista Avance y Perspectiva Consejo Editorial
Liliana Quintanar Vera Editora
Hiram Torres Rojo Corrección de estilo
Karina Galache Meléndez Arte y diseño
Agencia Idea Segura Diseño e impresión
Guillermo Elizondo Azuela Yolanda Freile Pelegrín
Francisco Alfredo García Pastor
Claudia González Espinosa
Ana Lorena Gutiérrez Escolano
Gabriel Merino Hernández
Marcos Nahmad Bensusan
Gabriela Olmedo Álvarez
Oscar Rosas-Ortiz
Moisés Santillán Zerón
Luz Manuel Santos Trigo
Patricia Talamás Rohana
Franco Bagnoli
Rosa María Herrera

Información de la artista:
http://avanceyperspectiva.cinvestav.mx revista@cinvestav.mx
RevistaAyP
RevistaAvanceyPerspectiva avanceyperspectiva
Foto de portada: obra de arte de Elena Gómez Toussaint, quien estudió Artes Plásticas en La Esmeralda, Ciudad de México y en la Escuela Nacional Superior de Bellas Artes de París, Francia. Su obra se ha presentado en varias exposiciones en México, Francia, Bélgica, Suiza, España, Irlanda y Reino Unido. Reproducción de la imagen con autorización de la artista. Instagram: @elenagomeztoussaint Correo: elenagtoussaint@gmail.com
Avance y Perspectiva, Volumen especial impreso 2024, órgano oficial de difusión editado por el Centro de Investigación y de Estudios Avanzados del Instituto Politécnico Nacional (Cinvestav). Av. Instituto Politécnico Nacional No. 2508, Col. San Pedro Zacatenco, Delegación Gustavo A. Madero, C.P. 07360, Ciudad de México, Tel. 5557473800, www.cinvestav.mx, revista@cinvestav.mx, Editora Responsable: Liliana Quintanar Vera, Reserva de Derechos al uso exclusivo: 04-2024-081911274500-102, Número ISSN: 0185-1411, ambos otorgados por el Instituto Nacional del Derecho de Autor. Responsable de la última actualización de este número, Cinvestav, a través de Liliana Quintanar Vera. Distribución gratuita por Cinvestav, Av. Instituto Politécnico Nacional No. 2508, Col. San Pedro Zacatenco, Delegación Gustavo A. Madero, C.P. 07360, Ciudad de México. Fecha de última modificación, 6 de septiembre de 2024. Impreso por Idea Segura, Cantera 6, Pedregal de Santo Domingo, Delegación Coyoacán, C.P. 04369, Ciudad de México. Este número se terminó de imprimir en septiembre de 2024, con un tiraje de 5,000 ejemplares. Los contenidos de los artículos y reseñas publicados son responsabilidad exclusiva de los autores y no representan necesariamente la opinión de los editores, ni de la institución. Servicio de imágenes por archivo Cinvestav y Envato. Se autoriza la reproducción parcial o total del contenido, por cualquier medio, siempre que se cite la fuente.
Con gran gusto y entusiasmo les presentamos el primer volumen impreso de Avance y Perspectiva desde su última edición en papel. La revista de divulgación científica del Cinvestav transitó del papel a lo digital en el 2018, bajo la dirección de su editor en ese momento, el Dr. Carlos Ruiz, a quien agradecemos tal circunstancia que permitió a la revista continuar entregando contenidos a sus lectores, aún en los tiempos difíciles de la pandemia causada por la COVID-19. Hoy estamos habituados a la vida en el ámbito digital, a sostener reuniones y comunicarnos a través de diversas plataformas digitales, y a que no siempre las cosas sucedan en formato físico y presencial. Sin embargo, el apego a lo material es un aspecto inherente del ser humano, y no falta quien anhele los tiempos en que se leía Avance y Perspectiva en papel, mientras que el salto hacia lo digital llegó para quedarse. Con este volumen impreso queremos compartir algunos de los artículos más leídos publicados por la comunidad Cinvestav en la era digital 2018-2023. La selección fue realizada por nuestro Consejo Editorial, cuidando tener un conjunto de artículos en los que se vean representadas, en la medida de lo posible, las diferentes sedes de nuestro centro y las diversas áreas de investigación que se cultivan en Cinvestav (ver mapa en páginas 30-31). Los 14 artículos seleccionados nos ofrecen un viaje fascinante desde los eclipses y los cráteres de la Luna, hasta un átomo que se sintió electrón, pasando por temas tan actuales como la biotecnología y la virología. Se incluyen temas característicos de algunas sedes, por ejemplo, los estudios moleculares del axolotl que se desarrollan en la Unidad de Genómica Avanzada, o la investigación de algas y sargazo que se realiza en la Unidad Mérida. Obviamente no es posible incluir todo el quehacer científico de Cinvestav en 60 páginas; al final sugerimos artículos que pueden leerse en nuestro portal, invitándolos a navegar entre lo digital y lo impreso en esta nueva era híbrida de Avance y Perspectiva. Con este volumen celebramos la relevancia y la diversidad de la labor científica que se desarrolla en Cinvestav, e invitamos a nuestros lectores a acercarse a conocer este acervo científico invaluable de nuestro país.
Liliana Quintanar Vera
Víctor José Sosa Villanueva
Departamento de Física Aplicada, Unidad Mérida, Cinvestav.

¿Cuántos de los lectores de este artículo han presenciado un eclipse total de Sol? No en fotos ni en filmaciones sino en el sitio y en el momento precisos en que la Luna obstruye por completo la luz solar. Seguramente el porcentaje de personas que ha sido testigo de este acontecimiento astronómico es muy bajo, porque es visible en un punto determinado y muy esporádicamente. Para dar una idea de lo que esto significa, baste decir que el eclipse total de Sol más reciente que se pudo apreciar en nuestro país, aconteció hace más de treinta años.
¿En qué consiste un eclipse de Sol?
La palabra eclipse proviene del griego ekleipsis (desfallecimiento), y significa la falta, ya sea del Sol o de la Luna. Un eclipse de Sol ocurre cuando, al interponerse entre el Sol y la Tierra, la Luna proyecta una sombra que cubre una estrecha franja de la superficie terrestre, como se ilustra en la Figura 1 (franja de
color verde). La obstrucción del paso de los rayos solares ocasiona que la luz del día se convierta durante unos minutos en una sensible oscuridad.
Si el disco de la Luna tapa por completo al Sol, la sombra será completa y esta-
remos en presencia de un eclipse total Además, existen franjas aledañas en donde la oscuridad no es total (Fig. 1). En esas regiones se observa un eclipse parcial. La oscuridad durante éste, es mayor en medida que se está más cerca de la franja del eclipse total.

En contraparte, la Tierra también llega a interponerse entre la Luna y el Sol, dando pie al oscurecimiento de nuestro satélite, lo cual constituye un eclipse de Luna. Este
fenómeno no es privativo de nuestro entorno; seguramente los eclipses ocurren también fuera del Sistema Solar cuando se conjugan los factores necesarios.
La trayectoria que sigue nuestro satélite natural alrededor de la Tierra es una elipse. Debido a ello, la Luna puede estar tan cerca como 356,000 km (se dice que está en su perigeo) o tan lejos como 406,000 km (apogeo). En consecuencia, la sombra proyectada durante un eclipse puede cambiar. En su apogeo o muy cerca de él, su superficie aparente en el cielo no es suficiente para cubrir todo el Sol, dejando un anillo de luz a su alrededor (Fig. 2); así, se dice que ocurre un eclipse anular. Si la Luna no está cerca de su apogeo, podrá tapar por completo la luz solar y se producirá un eclipse total normal. Los eclipses de Sol ocurren con cierta regularidad, entre 2 y 5 veces por año. Las zonas donde se observan son más bien estrechas (menos de 270 km), en contraparte con los eclipses de Luna, que son visibles prácticamente en la mitad de la Tierra.

3. Zonas donde se observó un eclipse total entre los años 1901-1920. Las trayectorias de color rojo corresponden a los eclipses anulares y las azules a los eclipses totales. Los tramos ascendentes y descendentes se deben a la inclinación del eje de rotación de la Tierra [1].
¿Cada cuándo se ha podido observar un eclipse total de Sol en México? En la figura 3 se muestran las zonas de la Tierra donde fueron visibles los eclipses ocurridos entre 1901 y 1920. Como puede apreciarse, solamente en una ocasión la sombra pasó por México; ello significa que las oportunidades de presenciar un eclipse total de Sol son muy escasas. Cabe mencionar que la sombra de la Luna siempre se desplaza de Oeste a Este.
Tamaños y distancias a la Tierra de la Luna y el Sol
Un eclipse total de Sol es producto de una combinación astronómica entre nuestro Sol y la Luna. Por una parte, los diámetros de la Luna y del Sol son de 3,474.8 km
y 1,392,700 km respectivamente. Es decir, el tamaño del Sol es prácticamente 400 veces el tamaño de la Luna. Por otra parte, las distancias medias entre la Tierra y la Luna y el Sol son de 384,600 km y 150,000,000 km, respectivamente. Es decir, el Sol está 390 veces más lejos de nosotros que la Luna.
La similitud entre estas cantidades (400 y 390) conduce a que ambos astros tengan prácticamente el mismo tamaño aparente vistos desde la Tierra, y cuando la Luna se interpone entre el Sol y nosotros obstruye en su totalidad la luz solar. En mi opinión, esta es la coincidencia más sorprendente que existe en la naturaleza. En la Figura 4 podemos apreciar una extraordinaria fotografía tomada desde el espacio de la sombra de la Luna durante uno de estos fenómenos.
En la historia de la humanidad se han producido eclipses de Sol especialmente notables. En la Biblia (Lucas 23, 44-45) está escrito que, al momento de morir Jesucristo, “el Sol se oscureció durante 3 horas”. Sin embargo, no figura en los anales históricos algún eclipse de Sol visible en Jerusalén en esa época. Solamente está registrado un eclipse de Luna el 3 de abril del año 33 (Jesucristo murió a los 33 años). Es difícil establecer alguna explicación de esa oscuridad basándose solamente en esta información.
En 1135, un eclipse total de Sol visible en Inglaterra coincidió con el fallecimiento del rey Enrique I, lo cual despertó temor en la población ya que había una gran conexión del pueblo con la Iglesia. Este eclipse se conoce como “el eclipse del rey Enrique”. En mayo de 1919, el físico Arthur Eddington fotografió la ubicación de las estrellas en posiciones muy



cercanas al Sol durante un eclipse total, y comprobó la desviación que sufre la luz al pasar cerca de una gran masa, una de las predicciones de la Teoría General de la Relatividad de Albert Einstein.
Características de la sombra de la Luna durante un eclipse de Sol
La distancia Tierra-Luna varía entre 357,300 km y 407,100 km. Conociendo la distancia precisa al momento de ocurrir un eclipse, se determinan el diámetro de la sombra, su velocidad y el tiempo de duración del eclipse. También se especifica si el eclipse será total o anular, y la trayectoria que seguirá la sombra de la Luna.
El diámetro máximo de esa sombra (cuando la Luna está lo más cercana a la Tierra) es de 268.7 km. Para calcular la velocidad con la que se mueve durante el eclipse, hay que restar a la velocidad de traslación de la Luna (3,600 km/h), la velocidad (por la rotación terrestre) del punto donde se observa el eclipse. Esta última es máxima en el ecuador y muy pequeña en las cercanías de los polos. De manera que la velocidad de la sombra variará aproximadamente entre 1700 km/h y 3380 km/h.
El tiempo que dura el Sol completamente eclipsado se calcula fácilmente dividiendo el diámetro de la sombra entre su velocidad. Los eclipses totales más largos de los que se tiene registro han durado hasta 12 minutos.
Eclipses totales de Sol en México
En el territorio mexicano hemos podido observar este fenómeno en pocas ocasiones. En los últimos 100 años, de acuerdo con el catálogo de eclipses de la NASA https://eclipse.gsfc.nasa.gov/SEcat5/SE0001-0100.html, ocurrieron en 1923, 1940, 1970, 1984 y 1991. Cabe destacar que el eclipse de 1984 tuvo una duración de tan solo 11 segundos.
La buena noticia es que la gran escasez de eclipses totales de Sol en México tiene una etapa contrastante en 2023 y 2024. En efecto: el 14 de octubre de 2023 se tuvo la oportunidad de presenciar un eclipse anular en la Península de Yucatán. Por si fuera poco, el 8 de abril de 2024 ocurrió un eclipse total que fue visible en el norte de México. Las trayectorias que siguió la sombra de la Luna en ambos eventos, es decir, las zonas donde se observaron estos eclipses de manera total, se muestran en la Figura 5. Es importante mencionar que el siguiente eclipse total de Sol en México ocurrirá 28 años después, el 30 de marzo de 2052.
¿Qué se ve durante un eclipse total de Sol?
Tuve la oportunidad de presenciar los eclipses de 1970 y 1991. En el primero me tocó estar en la zona de penumbra, y aunque no se oscureció totalmente, pude observar algunos fenómenos aso-
ciados. Recuerdo la sombra anormal de las hojas de los árboles, un fenómeno óptico ocasionado por la obstrucción parcial de la luz solar.
El eclipse de 1991 ocurrió en el Valle de México alrededor de la 1 de la tarde. A esa hora, las estrellas brillaban y se escuchaban a los gallos cantar y ladrar a los perros. También se veían los pájaros volar hacia los árboles. En las zonas rurales pudo apreciarse un crepúsculo en el horizonte. Descendió la temperatura y surgieron las sombras volantes en el suelo (como las que vemos en el fondo de una piscina). Es decir, estar en la zona de la totalidad del eclipse permite apreciar el fenómeno de una forma mucho más completa que la que se puede tener estando en la zona de la penumbra. Artículo publicado en línea el 27 de junio de 2023.

Referencias
1. Sitio de la NASA que contiene toda la información de los eclipses solares ocurridos entre 1999 a.C. y 3000 d.C.: https://eclipse.gsfc.nasa.gov/ solar.html
Paula Cintrón-Núñez y José Gerardo
Cabañas-Moreno
Programas Multidisciplinarios,
Unidad Zacatenco, Cinvestav.

La combinación de diferentes elementos donde la mayoría son metales, se conoce como aleaciones metálicas; típicamente contienen solo uno o dos componentes principales —por ejemplo, bronce (Cu+Sn) y latón (Cu+Zn)— con el fin de evitar la presencia de numerosas fases diferentes, ya que microestructuras complejas normalmente se asocian con materiales difíciles de procesar. Sin embargo, en 2004, el concepto de aleaciones de alta entropía (HEA, por las siglas en inglés “High-Entropy Alloy”) fue propuesto por Yeh [1] y Cantor [2] para aleaciones multicomponentes con composiciones aproximadamente equiatómicas (esto es, en iguales proporciones atómicas de los elementos presentes). Así, una aleación HEA con Ti, V, Cr y Mo contiene aproximadamente 25% atómico de cada uno de estos elementos. Al contrario de lo que usualmente se pensaba, estas aleaciones tienden a formar un número reducido de fases, en particular del tipo de soluciones sólidas (SS) con estructuras cristalinas sencillas (cúbicas o hexagonales).
En las SS multicomponentes, las posiciones de los átomos de cada elemento son aleatorias, lo que es equivalente a un alto grado desorden. El concepto termodinámico de entropía frecuentemente se visualiza como una medida del grado de desorden de un sistema; además, la segunda ley de la termodinámica establece que la entropía de un sistema siempre va en aumento. Por otra parte, la estabilidad de un material puede evaluarse en términos del cambio en la energía libre de Gibbs (ΔG) a temperatura y presión dadas, la cual se expresa como:
ΔG = ΔH – TΔS (1)
donde ΔH es la entalpía, T la temperatura absoluta y ΔS la entropía. En términos simplificados, a presión constante, ΔH es el calor de formación que puede ser negativo (exotérmico – la formación desprende calor) o positivo (endotérmico – la formación requiere calor). La estabilidad de una fase se incrementa conforme se hace más negativa, por lo que el término TΔS de la ecuación contribuye en ma-
yor medida a la estabilidad termodinámica de una fase conforme incrementa su valor (siempre positivo). Esta es la razón de ser de las HEA con SS de estructuras cristalinas sencillas.
Por otra parte, la denominación alta entropía indica que la magnitud de ΔS en el sistema, es mayor que la presentada en aleaciones convencionales. Dada una SS ideal, la entropía de mezcla (ΔSmix) puede calcularse a partir de la ecuación de Boltzmann:

ΔSmix = kln w (2)
donde k es la constante de Boltzmann (1.380649×10-23 J/K) y w es el número posible de configuraciones de las partículas del sistema. Por lo tanto, ΔSmix (por mol) para la formación de una SS de N elementos con fracciones atómicas Xi es:
(3)
donde R es la constante de los gases ideales, (8.314 J/K mol). De acuerdo con la ecuación (3), ΔSmix para una aleación es máxima cuando los elementos están en composiciones equiatómicas; además, su valor aumenta con el número de elementos (N) en el sistema. Así, tenemos que:
(4)
Valores de ΔSmix calculados con la ecuación (4) se muestran en la Tabla 1. Como se señala, el valor de ΔSmix aumenta rápidamente cuando N<9; mientras que valores de N mayores a 9 no suponen un cambio significativo en el cálculo de ΔSmix

Tabla 1. Entropías de mezcla en términos de R para aleaciones equiatómicas con 1 y hasta 13 elementos, calculadas de acuerdo con la ecuación (4).
A modo de comparación, una aleación comercial de acero inoxidable 304 cuya composición en porcentaje atómico es 69% Fe, 19% Cr, 9% Ni, 1% C y 2% Mn (Tabla 2), en el caso de ser una SS de todos los elementos (que no lo es), tendría valor de ΔSmix ideal de 0.91R, es decir, un 56.5% del valor calculado en la Tabla 1 para cinco elementos. Con base en lo anterior, la definición de la composición de las HEA puede explicarse —hasta cierto punto— a partir del cálculo de la entropía de mezcla.
Aleación
Acero inoxidable SAE 304
Composición (% a t.) mix
Aleación de Aluminio 2024 0.91 0 38
Tabla 2. Entropías de mezcla en términos de R para dos aleaciones comerciales, calculadas de acuerdo con la ecuación (4).
La estructura de una SS ideal de cinco componentes se ilustra en la Figura 1a. En ella se representa una distribución al azar de los distintos elementos de la aleación, cuya estructura se diferencia claramente de la Figura 1b, correspondiente a un compuesto intermetálico (IM) de estequiometría TiCr2. En este último se observa que los átomos de Ti y Cr ocupan posiciones particulares en la estructura cristalina. En términos de la entropía de mezcla, la estructura de la SS tiene mayor valor de ΔSmix (mayor desorden) que el valor para el compuesto TiCr2 (mayor orden). Y como se muestra en la Tabla 1, ΔSmix para una SS aumenta con el número de componentes N, con lo que la contribución entrópica se hace más importante al aumentar N.
Figura 1. Estructuras cristalinas de a)
SS de cinco componentes y b) TiCr2 Ti Cr



El trabajo inicial de HEA se dio a conocer en 2004 [1], cuando se introdujeron los términos “aleaciones de alta entropía” (HEA) y “aleaciones de elementos principales múltiples” (MPEA). Desde entonces, el interés en el estudio de HEA ha aumentado significativamente. La Figura 2 exhibe el crecimiento del número de publicaciones anuales en revistas indexadas en una búsqueda en Scopus de los términos “high entropy alloy” o “multi-principal element alloy” localizados en el título, las palabras clave, o el resumen. El interés no proviene directamente de las estructuras cristalinas que se forman, sino de las diversas propiedades que se han observado en estos materiales.
Hasta la fecha, la mayoría de los sistemas estudiados son aquellos basados en metales de transición 3d (Co, Cr, Cu, Fe, Mn, Ni), los cuales suelen formar fases cúbicas centradas en las caras. También es frecuente agregar a este tipo de HEA elementos como Al, Ti y Mg, con lo que se tornan en aleaciones más ligeras. Otro tipo de HEA de considerable interés han sido las llamadas HEA de metales refractarios (Zr, Nb, Mo, Ru, Hf, Ta, W), en especial por ser elementos de alta temperatura de fusión. En este tipo de aleaciones, la estructura de las SS frecuentemente es cúbica centrada en el cuerpo.
Debido a su carácter multicomponente y amplio rango de composiciones, es evidente la enorme cantidad de combinaciones posibles en HEA, las cuales no es viable abordar únicamente a través de prueba y error. Por ello, se han usado herramientas computacionales como CALPHAD (cálculos de diagramas de fase), cálculos ab initio, y “machine learning”, entre otras, con el propósito de predecir algunas de sus características y propiedades principales (p. ej., fases estables, resistencia mecánica, o propiedades catalíticas) y disminuir significativamente el número de diferentes composiciones de HEA potencialmente útiles.
Como se mencionó, las HEA se han investigado principalmente por el interés en sus propiedades mecánicas y estructurales. Sin embargo, crece notoriamente la atracción por desarrollar materiales de alta entropía en áreas como magnetismo, almacenamiento de hidrógeno, resistencia a la corrosión, termoelectricidad, superconductividad, catálisis e implantes biomédicos. Algunas aplicaciones potenciales se enumeran a continuación:
Figura 2. Análisis de tendencia en las publicaciones de HEA y MPEA entre 2004 y 2024 (hasta julio). Fuente: Scopus.
• Imanes blandos para transformadores, generadores y motores.
• Materiales catalíticos para diferentes reacciones como la descomposición del agua, la reducción electroquímica de CO2, la oxidación de hidrazina, la descomposición de colorantes, entre otras.
• Recubrimientos para prolongar la vida útil y mejorar la resistencia a la corrosión, oxidación y al desgaste de partes móviles como rodillos de excavadoras y bulldozers, cucharones excavadores, herramientas de corte, etcétera.
• Aleaciones para estructuras de reactores nucleares de cuarta generación con alta tenacidad a temperaturas ≥ 850 °C, resistencia a la oxidación y al daño por radiación.


• Materiales para troqueles y moldes de trabajo en caliente que soporten temperaturas de hasta 1200 °C.
• Activadores y catalizadores de dispositivos de detección con alta selectividad y la sensibilidad hacia analitos de detección (H2, trietalodamina, etcétera).
• Materiales para generadores de energía termoeléctrica.
• Almacenamiento de hidrógeno en estado sólido en forma de hidruros metálicos.
• Aleaciones para compresores, cámaras de combustión, boquillas de escape y diseño de álabes para turbinas de gas dentro del motor, como parte de sistemas de propulsión para misiones de exploración espacial.
Incluso, en años recientes el concepto fundamental de las HEA se ha extendido a “materiales de alta entopía” (HEM), tales como óxidos, carburos y cerámicos.
Paralelamente, se han comenzado a fabricar con éxito nanopartículas de aleaciones de alta entropía, por lo que la exploración de nuevas clases de HEA, auxiliada por herramientas computacionales para diseñar materiales con estructura y propiedades deseadas, continuará desarollándose en los próximos años, de manera que existen numerosas oportunidades para futuras aplicaciones de las HEA.
Artículo publicado en línea el 31 de julio de 2023.

Referencias
[1] Yeh J-W, Chen S-K, et al (2004). Nanostructured high-entropy alloys with multiple principal elements: Novel alloy design concepts and outcomes. Advanced Engineering Materials, 6(5), 299–303.
[2] Cantor B, Chang ITH, et al (2004). Microstructural development in equiatomic multicomponent alloys. Materials Science and Engineering: A, 375–377, 213–218.



Edad de Bronce 5,000 a. C.
Edad de Piedra 10,000 a. C.





Cobre/ Bronce



Edad del Acero 1,900
Edad de Hierro 1,000



Edad del Silicio 1,990
Edad de la Ingeniería Molecular 2010


Aleaciones acero Aleaciones ligeras Super aleaciones
Edad del plástico 1,960





Desarrollo paulatino Mayor calidad, control y procesamiento
AZUL
Océanos y mares
GRIS
Cuidado del medio ambiente


BLANCA
Procesos industriales

Paola A. Tenorio-Rodríguez y Yolanda Freile-Pelegrín
Departamento de Recursos del Mar, Unidad Mérida, Cinvestav.


En sentido estricto, la palabra biotecnología proviene del griego βίος [bíos], «vida», τέχνη [-tecne-], «destreza» y -λογία [-logía], «tratado, estudio, ciencia», y es entendida en su acepción más amplia y práctica como “el empleo de organismos vivos y sus productos para obtener un bien o servicio”. Para lograrlo, la biotecnología echa mano de diferentes ciencias como la química, la biología y la física; si bien la palabra pudiera sonar como algo moderno y de reciente creación, no es del todo correcto, pues el agrónomo húngaro Karl Ereky fue el primero en utilizar el término a finales de la década de 1910 [1]. Lo cierto es que esta ciencia surgió hace cientos de miles de años, probablemente desde el Paleolítico, cuando el Homo sapiens con su cerebro de 1,400 cm3 empezaba su transición de hábitos nómadas hacia los sedentarios. Una vez que dominó
Clasificación de la biotecnología por su color y aplicación. Los océanos constituyen más de dos terceras partes de nuestro planeta. Son fuente de abundantes y diversos recursos, además de los alimenticios. Debido a ello, la comunidad científica ha explorado estas zonas con el fin de producir bienes y servicios a partir de los mares, el desarrollo de nuevas moléculas terapéuticas, la producción de biocombustibles alternativos y no contaminantes, y la adaptación de la acuacultura en función de las necesidades sociales y ambientales, son tan solo una muestra de ellos.
el fuego y adquirió la capacidad para producir sus alimentos, cultivando vegetales y domesticando animales, fue el momento en el que la biotecnología se volvió compañera en la historia evolutiva del género humano.

VERDE Agricultura ROJO Medicina
AMARILLO
Alimentación y nutrición
Los conocimientos inicialmente empíricos de manejo y uso de procesos biológicos, hoy reconocibles dentro de la biotecnología, se utilizaban desde los comienzos de la historia de la humanidad y se relacionaban principalmente con la elaboración de alimentos, tal es el caso de la fermentación de bebidas como el vino o el pulque, la fabricación de quesos y la panadería. Posteriormente sucedió algo similar con el desarrollo de las vacunas, a través de las primeras observaciones del médico Edward Jenner (1749-1823), los postulados de Robert Koch en 1884, y el diseño, un año más tarde, de la primera vacuna de Luis Pasteur con base en microorganismos atenuados. Y qué decir de Mendel, sus experimentos con los chícharos y la postulación posterior de sus leyes en 1865 que permiten actualmente mejorar los procesos de selección intraespecies.
Si reflexionamos por un momento, caemos en la cuenta de que la biotecnología incide y tiene aplicaciones en todas nuestras actividades diarias, como humanos y como sociedad, desde el desarrollo de nuevas terapias y fármacos para el tratamiento de enfermedades clásicas y emergentes, como es el caso de COVID-19, pasando por el desarrollo de nuevos productos alimenticios (nutraceúticos o alimentos funcionales), y el manejo adecuado de residuos contaminantes para la sustentabilidad ambiental.
La historia nos confirma que para entender y usar la naturaleza, el Homo sapiens ha tenido la necesidad de organizar y clasificar lo que le rodea: fruta venenosa, no venenosa, fruta inmadura o madura, etcétera. Así también surge la tendencia de simplificar la biotecnología, tan amplia y con innumerables aplicaciones, categorizándola mediante colores para concretar sus usos y referirse a ellas de manera universal [2]. Sin duda, la más reconocida es la biotecnología verde, enfocada a la agricultura (plantas transgénicas, agentes insecticidas), pero sin desplazar a la roja, aplicada a medicina (terapia génica, vacunas, terapia celular); la amarilla, relacionada con la alimentación (nutraceúticos); la blanca, para usos industriales (biocombustibles, enzimas catalizadoras); la gris, aplicada al cuidado del medioambiente (saneamiento de suelos, reciclaje de sustancias residuales), y más recientemente, la azul, dirigida a los ambientes acuáticos. En definitiva, un auténtico arcoíris de posibilidades.
¿Qué puede hacer la biotecnología azul por nosotros? Muchísimas cosas. Por ejemplo, el descubrimiento a finales de los años 60 de una proteína verde fluorescente (GFP, por sus siglas en inglés), proveniente de la medusa Aequorea victoria, tuvo gran impacto en la biología celular; actualmente permite etiquetar otras proteínas y de esta forma obtener información sobre la localización, dinámica y cambios bioquímicos dentro y entre las células (desarrollo de redes neuronales, evolución de enfermedades como el cáncer o el Alzheimer, proliferación de ciertos virus, entre otros). Recientemente Europa aprobó la trabectedina, primer antitumoral de origen marino del mundo, obtenido del tunicado Ecteinascidia turbinata y que
La biotecnología azul, también conocida como biotecnología marina, es una disciplina basada en el estudio de las propiedades de los organismos marinos, sus genomas y uso potencial y desarrollo de productos derivados para aplicarse en diferentes áreas en beneficio del ser humano.
hoy se comercializa con el nombre de Yondelis® en más de 80 países. Otro ejemplo notable es el compuesto ziconotide, extraído de un gasterópodo del género denominado Conus y usado en el tratamiento del dolor crónico. El fármaco comercializado con el nombre de Prialt® posee ventajas importantes: no produce dependencia ni desarrolla tolerancia y tiene un potencial analgésico muy superior a la morfina [3]. Los vegetales marinos también detentan un papel protagónico en la biotecnología azul. El alga verde Ulva lactuca se utiliza como material de sustitución de la sílice amorfa en la fabricación de llantas para automóviles, tecnología patentada por la empresa italiana Pirelli [4]; será cuestión de tiempo ver estas llantas rodar en las calles.
En el océano las algas están sometidas a variaciones constantes en el medio que habitan: la luz que reciben, la temperatura, salinidad y nutrientes donde crecen y el oleaje y mareas que las mecen. Como forma de adaptación a este medio variable, han desarrollado una gran capacidad para producir numerosos compuestos y metabolitos, a veces únicos, que pueden compensar estos cambios y fluctuaciones. Así, la producción de

diversos compuestos entre los que encontramos ciertos pigmentos, fenoles, terpenos, polisacáridos, esteroles, proteínas, aminoácidos y lípidos, garantiza su supervivencia en estos ambientes. Es relevante señalar que muchas de las moléculas producidas por las algas muestran también diferentes actividades biológicas, por lo que pueden funcionar como agentes antioxidantes, antitumorales y antivirales. Es por ello que las algas marinas se convierten en importantes reservorios de nutrientes y de sustancias bioactivas, siendo una fuente potencial de nutracéuticos, es decir, alimentos o ingredientes alimentarios que benefician a la salud más allá de su valor nutritivo [5].
De acuerdo con la Organización de las Naciones Unidas (ONU), para el 2050 seremos casi 10,000 millones de personas habitando el planeta. En este contexto, el cultivo de algas marinas para obtener biomasa abundante se considera como una posible solución para satisfacer la demanda de alimento, además de coadyuvar a desafíos globales tales como la salud humana, contribuyendo a
una bioeconomía circular sostenible. En los últimos años, gracias a los avances de la biotecnología marina y la acuacultura se ha logrado establecer el concepto de acuacultura multitrófica integrada (IMTA, por sus siglas en inglés). Este concepto se basa en el cultivo, en un mismo sistema, de organismos de diferentes niveles tróficos, donde la excreción de estos especímenes de nivel superior, se convierte en un recurso utilizado por los niveles inferiores, creando así una cadena trófica que permite reducir la cantidad de residuos vertidos al ecosistema, mejorando la calidad del agua y la sanidad de los animales [6]. En los sistemas IMTA, la presencia de algas destaca debido a su capacidad de biofiltración, ya que maximiza la eficiencia de los recursos a la vez que proporciona una biorremediación natural en los sitios de cultivo, mejorando la calidad del agua al absorber los nutrientes. Los sistemas de acuacultura multitrófica contribuyen a hacer que la acuacultura sea más sostenible, competitiva y diversa, sin contar con que la biomasa algal obtenida puede tener un potencial valor económico. Los laboratorios de Ficología Aplicada
y Ficoquímica Marina del Cinvestav-Mérida se enfocan desde hace varios años en la fisiología y reproducción de algunas especies de algas marinas tropicales con potencial biotecnológico, lo que ha permitido conocer y desarrollar estrategias de crecimiento, cultivo y manipulación con miras a su aprovechamiento. A la par se realizan trabajos de valorización de las especies mediante la extracción de metabolitos con actividad biológica para su aplicación como fuente de compuestos con potencial nutracéutico y agentes terapéuticos. Se han obtenido resultados muy promisorios derivados del proyecto NUTRAMAR (Nutracéuticos de Algas Marinas Conacyt-2015-01-118) con las algas rojas Rhodymenia pseudopalmata (J.V.Lamouroux) y Solieria filiformis (Kützing) Gabrielson. Estas especies se integran exitosamente en un sistema IMTA (Figura 1), mostrando alta productividad y tasas de crecimiento, además de beneficios ambientales al disminuir las concentraciones de amonio en el agua proveniente del cultivo de otros organismos animales [7].
Aunado a lo anterior, la biomasa de estas dos especies puede ser manipulada tanto en su cultivo como durante su extracción, obteniendo con éxito compuestos bioactivos con actividad antioxidante [8,9] y antiviral [10]. Actualmente se trabaja en la actividad antidiabética y anticolesteronémica de sus extractos con el objetivo de identificar compuestos que pudieran ayudar a tratar y prevenir patologías como la obesidad y diabetes a través de la inhibición de las enzimas encargadas de la hidrólisis de carbohidratos y lípidos. No está por demás señalar que la presencia de estas dos enfermedades, aunada a la existencia de hipertensión da lugar al desarrollo del síndrome metabólico, catalogado como enfermedad no transmisible (ENT). Las ENT progresan lentamente y conducen a una reducción de la calidad de vida de los pacientes, así como a un aumento de la morbilidad y la mortalidad, generando un alto costo económico y social. Es importante señalar que, en lo referente a la seguridad alimentaria, las especies no muestran citotoxicidad ni acumulación de metales pesados como plomo (Pb), cadmio (Cd) y arsénico (As) que pudieran ser nocivos para la salud,
por lo que tendrían posibilidad de incluirse en la dieta alimenticia (Figuras 2 y 3).
Resultados del mismo proyecto NUTRAMAR sugieren que para Solieria filiformis la técnica de encurtido es uno de los procesamientos más adecuados desde el punto de vista nutricional para su eventual consumo. Además de obtener una atractiva coloración roja con esta técnica, la presencia del ácido graso monosaturado, ácido oléico (C18:1), componente principal del aceite de oliva usado en dietas saludables, se ve favorecido. Por lo anterior esta especie (S. filiformis) ha sido propuesta como una alternativa excelente y sustentable dentro un marco de biotecnología azul. Por ello, y a partir de los resultados obtenidos, se espera contribuir con un beneficio ambiental, de salud humana, nutricional y biotecnológico. Sin embargo, a pesar de los beneficios potenciales para nuestra salud la “pregunta del millón” surge… ¿comeremos algas? ¿nos gustarán?


Figura 2. Propuesta gastronómica del Chef Pedro Evía del restaurante K’u’uk para Solieria filiformis Foto: Yolanda Freile
Para responder algunas de estas preguntas, en 2021 se llevó a cabo un estudio prospectivo con la finalidad de obtener información sobre la percepción y actitud hacia el consumo de algas marinas como opción alimenticia en México. Como parte de la investigación se lanzó un cuestionario de alcance nacional. A la fecha de esta publicación aproximadamente 650 han respondido a la encuesta y los datos obtenidos se siguen generando y analizando estadísticamente para obtener una respuesta
Referencias
[1] Fári MG, Krazlovánsky UP (2006) The founding father of biotechnology: Károly (Karl) Ereky. International Journal of Horticultural Science 12 (1) 9-12.
[2] Da Silva, EJ (2004) The colours of biotechnology: science, development and humankind. Electronic Journal of Biotechnology 7(3) 1-2.
[3] Prommer E (2006) Ziconotide: a new option for refractory pain. Drugs Today 42 (6) 369-378.
[4] Cataldo F, Carrasco F, et al (2006) Procedimento e formulazioni per la preparazione di mescolanze mediante l’impiego di biomasse come ad esempio Ulva e ulvano come biopolimerinaturali e loro impiego nella fabbricazione di pneumatici e di altri manufatti in gomma”. Italia. Número de patente: 0001333847.
[5] Lopes D, Melo T, et al (2020) Valuing bioactive lipids from green, red and brown macroalgae from aquaculture, to foster functionality and biotechnological applications. Molecules 25 (17) 3883.
certera al potencial de las algas como alimento humano en México. Es interesante notar que los resultados preliminares parecen evidenciar que la falta de conocimiento e información son la principal barrera que evita que nos animemos a integrar a las algas marinas en nuestra alimentación diaria, dando la razón al refrán popular “no se puede comer lo que no se conoce”. De tal suerte, es necesario e imperativo impulsar la divulgación de las propiedades y beneficios para propiciar una mayor aceptación como producto marino alternativo.
La apuesta por este color de la biotecnología es uno de los grandes desafíos de la investigación en el contexto mundial en los años venideros. Desde luego, nos queda mucho por investigar, así que en esta ocasión no hay un colorín colorado… porque esta historia aún no ha terminado.
Figura 3. Propuesta gastronómica del Chef Pedro Evía del restaurante K’u’uk para Rhodymenia pseudopalmata. Foto: Yolanda Freile
Artículo publicado en línea el 7 de octubre de 2021.

[6] Neori A, Shpigel M (1999) Using algae to treat effluents and feed invertebrates in sustainable integrated mariculture. World Aquaculture 30(46–49) 51.
[7] Peñuela A, Robledo D, et al (2018) environmentally friendly valorization of Solieria filiformis (Gigartinales, Rhodophyta) from IMTA using a biorefinery concept. Marine Drugs 16, 487
[8] Zepeda E, Freile-Pelegrín Y, et al (2020) Nutraceutical assessment of Solieria filiformis and Gracilaria cornea (Rhodophyta) under light quality modulation in culture. Journal of Applied Phycology 32, 2363–2373.
[9] Pliego-Cortés H, Bedoux G, et al (2019) Stress tolerance and photoadaptation to solar radiation in Rhodymenia pseudopalmata (Rhodophyta) through mycosporine-like amino acids, phenolic compounds, and pigments in an integrated multi-trophic aquaculture system. Algal Research 41, 101542
[10] Peñuela A, Bourgougnon N, et al (2021) Anti-herpes simplex virus (HSV1) activity and antioxidant capacity of carrageenan-rich enzymatic extracts from Solieria filiformis (Gigartinales, Rhodophyta). International Journal of Biological Macromolecules 168, 322-330.
Por mucho tiempo la función exponencial ha jugado un papel fundamental en las matemáticas, y su impacto ha trascendido esta disciplina. En este artículo reseñamos su historia, partiendo desde las civilizaciones antiguas y examinando su evolución. Además resaltamos algunos de los hitos matemáticos que llevaron a la creación de la función exponencial. Finalmente, proporcionamos una mirada breve de cómo la función exponencial es utilizada en áreas como la física, ingeniería y biología.
Moisés Santillan
Unidad Monterrey, Cinvestav.
Cuenta una leyenda que el dios Krishna se presentó ante un rey personificando a un hombre sabio y lo retó a un juego de ajedrez, el juego favorito del rey. Antes de comenzar decidieron lo que sería el premio si ganaba el sabio. Éste dijo que sólo quería una pequeña cantidad de arroz que se calcularía utilizando el tablero de ajedrez. Un grano de arroz se colocaría en el primer cuadro y el número de granos se duplicaría en cada cua-

dro sucesivo. El rey al perder el juego, se vio obligado a cubrir su deuda. Sin embargo, al ir colocando los granos de arroz en el tablero, pronto se dio cuenta de que no tendría suficiente arroz para pagar. Krishna entonces, se reveló en su verdadera forma y le dijo al rey que podía pagar la deuda poco a poco, ofreciendo arroz gratuito en el templo todos los días hasta que la deuda estuviera completamente pagada.
Esta historia ha sido contada de muchas maneras diferentes con el pasar de los años. En algunas variantes, el personaje del dios Krishna es reemplazado por un siervo, el creador del juego de ajedrez, o un artesano que hace los mejores tableros de juego. En otras versiones se
usa trigo en lugar de arroz. También hay variaciones en el final de la historia; en algunas el gobernante mata a la persona que debería recibir el premio, mientras que en otras el premio se da sólo si se cuenta cada grano de manera individual. Sin embargo, el mensaje central de la historia sigue siendo el mismo: el aumento explosivo en un patrón donde cada paso se multiplica por la misma cantidad (progresión geométrica) en lugar de sumársele una cantidad fija (progresión aritmética).
Las raíces de las progresiones geométricas, una forma discreta de la función exponencial, se remontan a la antigua Grecia y posiblemente a los sumerios. Sin embargo, sería hasta el siglo XVIII que, gracias a algunos de los matemáticos más importantes del mundo, la función exponencial fue finalmente descubierta. A pesar de su corta edad, su impacto ha sido enorme y se extiende a muchos campos científicos. Para contar la historia de la función exponencial, es necesario empezar con la invención de los logaritmos.
Los logaritmos fueron creados de forma independiente por los matemáticos John Napier, de Escocia, y Jost Bürgi, de Suiza, con el objetivo de simplificar los cálculos en la trigonometría esférica, una herramienta utilizada en astronomía y navegación estelar. Aunque Bürgi probablemente creó su sistema de logaritmos alrededor del 1600, la descripción de Napier fue publicada primero, en 1614, en el libro Mirifici Logarithmorum Canonis Descriptio (Descripción del Maravilloso Canon de Logaritmos), y gracias a ello fue ampliamente reconocido como el inventor de los logaritmos y tendría gran impacto en su evolución.
Los logaritmos vinculan la multiplicación en los números reales positivos y la suma en los números reales. Napier en particular, definió sus logaritmos como la relación entre dos partículas que se mueven a lo largo de una línea: una con una velocidad constante, y la otra con una velocidad proporcional a la distancia desde un punto fijo. Aunque cumplía con el propósito para el que fue introducido, la definición del logaritmo de Napier, LogNap, era un tanto rebuscada e introducía algunas complejidades innecesarias en los cálculos. Para ilustrar lo anterior, podemos echar un vistazo a la manera en que se relaciona con el logaritmo natural, In:
LogNap(x) = –107In(x/107).
El matemático inglés Henry Briggs hizo dos visitas a Edimburgo en 1616 y 1617 para colaborar con John Napier. Durante sus conversaciones, discutieron y aceptaron la propuesta de Briggs para modificar los logaritmos de Napier. Después de su segunda visita, Briggs publicó en 1617 la primera tabla de sus logaritmos mejorados, conocidos actualmente como logaritmos comunes o base 10 (log10). Su uso se extendió rápidamente debido a la manera en que facilitaban la realización de cálculos complejos. Esto se debió en gran parte a que nuestro sistema de numeración se basa en potencias de 10.
En 1649 Alphonse Antonio de Sarasa, quien fue estudiante de Grégoire de Saint-Vincent, demostró que el área A(t) bajo la hipérbola xy = 1 entre x = 1 y x = t obedece la siguiente relación común a todas las funciones logarítmicas:
A(tu) = A(t) + A(u).
Los matemáticos de la época pronto se dieron cuenta de que esta característica podría llevar a la creación de un nuevo tipo de logaritmo. Así, Mercator publicó en 1668 su libro Logaritmotechnia, con las primeras tablas de lo que ahora se conoce como logaritmo natural.
El libro clásico de Leonhard Euler, Introductio in analysin infinitorum (Introducción al Análisis Infinito), publicado en 1748, marcó el paso final en el desarrollo de logaritmos. Antes de Euler, los logaritmos solían definirse utilizando el cálculo integral. Sin embargo, Euler cambió esto introduciendo la potenciación ax con base a en los números reales positivos, y a partir de esta función definió el logaritmo base a como la función inversa.
El trabajo revolucionario de Jacob Bernoulli en el tema de interés compuesto, abrió el camino para el descubrimiento de la constante que más tarde fue denotada como e por Euler. La contribución de Bernoulli se puede describir de manera concisa de la siguiente manera: considere el crecimiento del capital cuando se invierte a una tasa de interés anual del 100% y se capitaliza en intervalos de tiempo 1/n. Al final del año, el capital se habrá multiplicado por un factor de
Bernoulli demostró que a medida que aumenta el valor de n, este factor converge a un valor constante entre 2 y 3.
Euler amplió el trabajo de Bernoulli definiendo la función exponencial y el logaritmo natural de la siguiente manera:
exp(x) = lim n n n 1 + n n x
ln(x) = lim n 1 1 x
Además, Euler estableció que la función exponencial es una función de potenciación con base e, exp(x) = ex y que la función exponencial y el logaritmo son funciones mutuamente inversas.
En su libro A Mathematician’s Apology, Godfrey H. Hardy argumentó que una idea matemática es seria o significativa si puede conectarse de manera natural y clara con un gran número de otras ideas matemáticas. Así, es altamente probable que un teorema matemático serio, que conecta ideas significativas, conduzca a avances importantes en las matemáticas y en otras ciencias. Hardy utilizó como ejemplo la demostración de Pitágoras sobre la irracionalidad de √2, destacando cómo un teorema simple y elegante puede abrir nuevas vías para el desarrollo de las matemáticas.
La función exponencial es un excelente ejemplo de una idea matemática que ha dejado un impacto duradero, no solo en matemáticas, sino también en otros campos. Se considera una pieza clave para el avance de todas las áreas modernas de matemáticas. Además, sus aplicaciones son diversas y pueden verse en campos como la física, donde explica procesos que van desde el decaimiento radiactivo hasta la dinámica de poblaciones. En finanzas se utiliza en el modelado de tasas de interés y precios de acciones. La función exponencial también es un componente crítico en la ingeniería, donde es fundamental para el desarrollo de circuitos eléctricos, sistemas de control y de comunicación, solo por mencionar algunos ejemplos.
En Introductio in analysin infinitorum Euler introdujo la ecuación que lleva su nombre:
eix = cos x + isin x.
En especial, cuando x = π, esta fórmula conduce a la conocida identidad de Euler:
eix + 1 = 0, 1 + 1 n n

Esta historia ha sido contada de muchas maneras diferentes con el pasar de los años. En algunas variantes, el personaje del dios Krishna es reemplazado por un siervo, el creador del juego de ajedrez, o un artesano que hace los mejores tableros de juego.
que es considerada por muchos como una de las ecuaciones más hermosas de las matemáticas, ya que combina las tres operaciones matemáticas básicas (suma, multiplicación y potenciación) y relaciona 5 constantes matemáticas fundamentales (0, la identidad aditiva; 1, la identidad multiplicativa; la unidad de los números imaginarios, i, π y e). La identidad de Euler es un punto de convergencia de diversas disciplinas matemáticas, como la aritmética, la trigonometría y la teoría de números complejos.
La fórmula de Euler también ha sido de gran importancia en la física y la ingeniería a través, entre otros ejemplos, del análisis de Fourier, el cual permite descomponer funciones complejas en sumas de funciones trigonométricas simples y cuyas aplicaciones más significativas incluyen:
• Procesamiento de señales: en el análisis y manipulación de señales como las de audio, imágenes y voz.
• Compresión de imágenes: en algoritmos de compresión de imágenes para reducir la cantidad de datos necesarios para representar una imagen.
• Análisis espectral: en el estudio de los componentes de frecuencia de las señales, como las producidas por objetos vibratorios u ondas electromagnéticas.
• Diseño de filtros: en la creación de filtros electrónicos que eliminen frecuencias no deseadas de las señales.
• Transferencia de calor: en el análisis del flujo de calor en sólidos y fluidos.
• Mecánica cuántica: en el estudio del comportamiento de partículas en un estado cuántico.
• Sismología: en el análisis de la propagación de ondas sísmicas.
• Análisis electromagnético: en el estudio del comportamiento de campos electromagnéticos.
• Análisis de señales neuronales: en el estudio de los campos eléctricos y magnéticos emanados de la actividad cerebral.
• Análisis de la estructura de proteínas: para determinar la estructura de las proteínas mediante cristalografía de rayos X.
En conclusión, la función exponencial ha trascendido el ámbito de la teoría matemática y se ha convertido en una herramienta vital en diferentes campos. Su impacto ha sido inconmensurable en el desarrollo de las ciencias naturales y sociales y ha permanecido como una fuerza impulsora detrás de numerosos avances tecnológicos.
Los lectores interesados en una comprensión más profunda de la historia de las funciones exponenciales y logarítmicas encontrarán interesante la serie de artículos History of the Exponential and Logarithmic Concepts, publicados en 1913 en la American Mathematical Monthly, volumen 20, números 1 a 7.
Estos artículos pueden ser consultados de forma gratuita en Jstor en la siguiente URL: https://www.jstor.org/
Artículo publicado en línea el 31 de marzo de 2023.

Juan Fernando Méndez
Vázquez y Fabián
Fernández-Luqueño
Posgrados en Sustentabilidad de los Recursos Naturales y Energías, Unidad Saltillo, Cinvestav.
Actualmente los niveles de contaminación son considerados en la toma de decisiones solo en algunas ocasiones. Difícilmente se acepta que la explotación de los recursos naturales haya causado el deterioro de los ecosistemas, los cuales son nuestra riqueza, responsabilidad y herencia generacional. Por fortuna, con el tiempo se han logrado avances tecnológicos significativos mediante la experimentación o el modelado matemático, para generar conocimiento que enmiende nuestros errores y disminuya la degradación de los ecosistemas.
Uno de estos avances tecnológicos es la electroquímica, encargada de estudiar la transformación y aprovechamiento de la energía mediante reacciones químicas y sus diversas aplicaciones en la vida diaria. Algunas de estas aplicaciones son el almacenamiento de la electricidad y la remediación de sitios contaminados por diversas fuentes, las cuales han alterado el equilibrio del suelo, sus microorganismos y su vegetación.
Los sistemas electroquímicos (SEQ) son aquellos en los que se puede obtener y almacenar energía mediante reacciones químicas. La generación de energía se realiza a través de celdas voltaicas y galvánicas que generan un flujo de electrones mediante reacciones espontáneas de reducción y oxidación. El almacenamiento de energía se realiza en baterías, las cuales son conocidas como generadores secundarios debido a que para funcionar se les debe suministrar electricidad mediante un proceso de
a/batería
f/puente externo
b/cátodo (reducción)
c/ánodo (oxidación)
d/sales
carga [1]. Los SEQ constan de cuatro componentes indispensables, los cuales se muestran en la Figura 1.
Batería: presente en las celdas voltaicas para provocar las reacciones redox (Fig. 1a).
Electrodos: comúnmente son barras metálicas en las cuales se llevan a cabo las reacciones redox (oxidación y reducción), cambiando los estados de valencia. Son conocidos como: cátodo (-; Fig. 1b) y ánodo (+; Fig. 1c).
Electrolito: es una sustancia líquida que contiene sales disueltas (Fig. 1d) y favorece la formación de iones (Fig. 1e).
e/solución electrolítica
Figura 1. Componentes de un sistema electroquímico.
Puente externo: transporta los electrones a través de una conexión externa la cual cierra el circuito (Fig. 1f).
Como se indica en la Figura 1, la energía de la batería pasa hacia los electrodos y se llevan a cabo las reacciones redox dentro del electrolito (la reducción en el cátodo y la oxidación en el ánodo), separando al electrolito en iones que serán atraídos por las cargas de los electrodos y podemos obtener diversos compuestos gaseosos (e.g. hidrógeno y oxígeno de la hidrólisis del agua).
Por otro lado, si buscamos almacenar la energía producida por la reacción entre el electrolito y los electrodos necesita-
remos que el electrolito sea compatible con un electrodo para que se dé el flujo de iones y los electrones equilibren la reacción. Podemos aprovechar este flujo de electrones para almacenar la energía o usarla de forma directa. La electroquímica basa su funcionamiento en las leyes sobre electrólisis de Faraday, las cuales indican que la cantidad de material que será depositado de un electrodo a otro está relacionada con la corriente (flujo de electrones) y la masa atómica de los elementos. Estas dependen también de la concentración, presión y temperatura a las que operan los SEQ.
Los SEQ deben ser alimentados con electricidad, que es generada por fuentes de combustible tradicionales, las cuales tienen una eficiencia cercana al 40 % y emiten gases de efecto invernadero. Los SEQ juegan un papel fundamental en la transición energética de las fuentes convencionales de energía hacia el uso de las energías renovables debido a las intermitencias presentes en estas últimas (e.g. los sistemas fotovoltaicos requieren baterías para proveer electricidad durante la noche o los días muy nublados).
Es importante recordar que existen dos tipos de celdas: la galvánica y la voltaica. En la primera ocurren reacciones espontáneas de las que se puede obtener una corriente eléctrica debido a la diferencia de potenciales (voltaje) entre los electrodos. En las celdas voltaicas es necesario proveer energía eléctrica para que se den las reacciones redox. La electroquímica se emplea a gran escala en la industria debido a sus aplicaciones tan diversas como la galvanoplastia (recubrimiento de metales para evitar corrosión), la electrólisis del agua (descomposición de la molécula del H2O en los gases hidrógeno [H2] y oxígeno [O2] en una celda voltaica), así como la obtención de diversos componentes gaseosos como el cloro.
Los principios electroquímicos (atracción de los iones positivos o negativos a los electrodos respectivos) se han empleado en la gestión ambiental a través
La electroquímica es un área del conocimiento que brinda beneficios a la sociedad a través de la generación y almacenamiento de energía, la limpieza de sitios contaminados, la síntesis de nuevos materiales y el aprovechamiento de recursos minerales
de la electrocoagulación de tintas, la desalinización del agua para el consumo humano, entre otros.
Por último, pero no menos importante, se encuentra la aplicación electrocinética para la remediación de los suelos (Figura 2), la cual consiste en suministrar una corriente directa a los electrodos distribuidos en la superficie del suelo, adicionando agua o algún electrolito como hidróxido de sodio (NaOH) para optimizar el transporte de los contaminantes a los electrodos y facilitar el contacto entre estos. La diferencia de voltaje entre los electrodos da paso a la electrólisis del agua, produciendo iones hidrógeno (H+) e hidroxilos (OH–); el H+ migra al ánodo a través del suelo
y los OH– al cátodo. Dependiendo de esta migración, muchos procesos fisicoquímicos que son controlados por el pH se verán afectados. Entre ellos están la absorción, desorción, disolución, precipitación, oxidación y reducción de los contaminantes. Para evitar la modificación del pH del suelo cercano al electrodo se recomienda cambiar la polaridad de los electrodos, ya que estos acidifican o alcalinizan el suelo cercano a ellos. Además, es de vital importancia conocer las características fisicoquímicas del suelo ya que la capacidad de intercambio catiónica, la permeabilidad y la conductividad eléctrica afectarán el desempeño de la electrocinética.
La selección de los electrodos para la electrorremediación se basa en la naturaleza de los contaminantes, pues los metales pesados han sido removidos con gran eficacia al usar electrodos de titanio. Además, los electrodos deben ser inertes para evitar la incorporación de nuevos contaminantes por el desgaste de estos. El campo eléctrico de los electrodos conduce los contaminantes hacia ellos a través de los siguientes mecanismos: electroósmosis, electromigración y eletroforesis. La electroósmosis es el desplazamiento del líquido inducido por el campo eléctrico, con respecto a la superficie sólida. La electromigración es el movimiento de especies iónicas disueltas y la electroforesis es el desplazamiento de partículas coloidales en suspensión. Generalmente, durante la electrorremediación, los tres mecanismos descritos previamente se desarrollan al mismo tiempo.
Los SEQ para la remediación electrocinética son seguros porque se suministran corrientes del orden de 1 a 3 volts por cm y se emplean electrolitos no tóxicos [2]. Además, se pueden tratar diversos contaminantes, orgánicos o inorgánicos, en distintas fases (sólido, liquido o gaseoso). Igualmente, la electrorremediación de suelos se ha empleado junto con otras técnicas como la fitorremediación (remediación de suelos mediante el uso de plantas), observando que la aplicación de electricidad ayuda a la degradación y fitoestabilización de los contaminantes. Sin embargo, es necesario realizar estudios sobre la acción de la electricidad en el crecimiento de las plantas y los efectos en los meso y microorganismos del suelo.
Figura 2. Proceso simplificado de remediación de suelo por electrocinética o electrorremediación de suelos. Los contaminantes migran hacia los electrodos, debido a la polaridad y a la hidrolisis del agua. La molécula del agua (color azul en dos tonos) indica que el suelo debe estar húmedo (Diseño de autores).
La remediación electrocinética o electrorremediación puede usarse para:
Remoción de iones metálicos por electromigración.
Remoción de especies volátiles y semivolátiles al incrementar la temperatura.
Remoción de especies aniónicas con la adición de surfactantes. Este proceso es conocido como EKSF por sus siglas en inglés (electrokinetic soil flushing).
Reducción en la concentración de metales pesados en lodos.
Remediación de suelos contaminados por pesticidas.
Como se ha indicado, la electroquímica puede adaptarse para diversos procesos en la industria química, metalúrgica, energética y ambiental. Por consiguiente, la electroquímica es un área del conocimiento que seguirá brindando beneficios a la sociedad a través de la generación y almacenamiento de energía, la limpieza de sitios contaminados, la síntesis de nuevos materiales y el aprovechamiento de recursos minerales, entre otros.
Artículo publicado en línea el 3 de junio de 2020.

[1] S. Bebelis K, Bouzek A et al (2013), Highlights during the development of Electrochemical Engineering. Chemical Engineering Research and Design, 1362, 1-74.
[2] Sánchez V, López-Bellido F et al (2018), Can electrochemistry enhance the removal of organic pollutants by phytoremediation? Journal of Environmental Management, 225, 280-287.

Daniel Robledo y Erika Vázquez-Delfín
Departamento de Recursos del Mar, Unidad Mérida, Cinvestav.
El Mar de los Sargazos, siempre envuelto en misterio y objeto de interés durante la antigüedad, hoy en día sigue despertando inquietud entre las diversas áreas del conocimiento. Oceanógrafos, físicos, geólogos y biólogos han planteado una serie de cuestionamientos alrededor de esta región; ahora, ante el crecimiento excesivo de algas flotantes, también llamadas pelágicas, y su acumulación masiva en las costas del Caribe, las preguntas aumentan. Algunas de ellas continúan sin respuesta.
El nombre del “Mar de los Sargazos” fue supuestamente otorgado por Cristóbal Colón o por alguno de los marineros portugueses que lo acompañaban. El significado botánico del término argaço,
probablemente deriva de alga, vía algaço, palabra sistemáticamente utilizada en documentos antiguos para designar indiferenciadamente a las algas marinas. De uso más reciente, el término sargaço, deriva, de acuerdo con el Diccionario de la Lengua Española, de argaço y del latín Salix, este último, nombre científico con el que se designa a los sauces conocidos coloquialmente como ‘sarga’ y cuya semejanza morfológica externa podría ser el origen de esta denominación. Otro posible término relacionado viene del portugués sal o salgado, que significa salado, de acuerdo con estudios etnográficos y lingüísticos [1]. Sea como fuere, ‘sargazo’ es el nombre genérico y coloquial con el que se denomina a las especies de macroalgas marinas; sirva como ejemplo el término ‘sargazo gigante’ (Macrocystis pyrifera) o ‘sargazo rojo’ (Gelidium robustum) con el que se conoce a dos especies de algas marinas aprovechadas en el noroeste de México. Recientemente, este término es empleado por los medios para referirse al fenómeno de arribazones masivas y recurrentes de la macroalga marina del género Sargassum.
El Mar de los Sargazos (Figura 1), comúnmente conocido como giro subtropical del Atlántico Norte, es una región donde una inmensa masa de agua queda delimitada por un vasto sistema de corrientes circulares que fluyen de este a oeste (Corriente Norecuatorial) y de oeste a este (Corriente del Golfo). Los vientos y el clima se combinan para dar a estas aguas una identidad muy particular; desde el punto de vista físico son aguas de mayor temperatura y salinidad, y desde el punto de vista biológico son hábitat de una gran cantidad de algas pelágicas del género Sargassum. El origen del Sargassum que habita el Mar de los Sargazos es incierto. Si bien se creía que provenía de poblaciones naturales de aguas costeras, en 1838 el botánico alemán F.J. Meyen anticipó la teoría de que los sargazos pasaban su ciclo vital en el mar abierto, que eran pelágicos, a diferencia de otras algas que crecen adheridas a las rocas. Fue hasta 1930 que A. Parr reportó que únicamente dos de las ocho variedades de sargazo encontradas en el Mar de los Sargazos componían el 90% del total de algas y todo el material analizado carecía de órganos reproductivos [2]. Es decir, que estas algas se hallaban pre adaptadas para vivir en mar abierto en una existencia flotante, cuya reproducción era asexual mediante fragmentación del talo, en donde cada segmento puede originar una nueva planta. Los primeros botánicos les dieron el nombre de Sargassum bacciferum, del latín bacca baya y del griego pero, llevar, es decir que lleva bayas, en alusión a las vesículas de flotación que acompañan al alga y que le permite mantenerse en la superficie y facilitar su desplazamiento y transporte por efecto de las corrientes marinas y el viento. Estas características sirvieron para que en 1927 Irving Langmuir explicara que el acomodo de las hileras de sargazos se debía al efecto de la convección o celdas verticales (celdas Langmuir) que giran perpendiculares a la superficie y que obligan a cualquier material flotante a permanecer en la superficie del mar.
Según su coloración, las masas flotantes de macroalgas marinas son conocidas en el medio científico como “mareas doradas”, cuando proliferan especies de algas pardas como Sargassum, o “mareas verdes” cuando están formadas por algas verdes principalmente del género Ulva Estas mareas son cada vez más frecuentes y comunes y ocurren indistintamente en las costas de Asia, Europa y América. Toneladas de estas algas pueden quedar depositadas en las playas, generando eventos de arribazones masivas. Se sabe que estas arribazones son fenómenos

1. Mapa antiguo del Mar de los Sargazos (1891) elaborado por el Dr. Otto Krümmel.
naturales que ocurren estacionalmente y que se deben tanto a factores biológicos (ciclos de vida, reproducción y senescencia; crecimiento, elongación y aumento de biomasa), como a los efectos ambientales por fenómenos climatológicos (tormentas, corrientes, marejadas y vientos) que desprenden a las algas del sustrato donde se fijan para ser arrastradas hacia las costas. No obstante, en algunas regiones del mundo, diversos factores adicionales, como incremento en los nutrimentos en el agua de mar o en la temperatura superficial del mar y cambios en los patrones de corrientes, generan acumulaciones algales masivas que producen afectaciones severas a los ecosistemas costeros. La magnitud y frecuencia de los eventos de arribazones masivas de sargazo reportados desde 2014-2015 en las costas del Caribe Mexicano no tienen parangón, y podrían tener su origen en el impacto de las transformaciones humanas en el entorno cercano a la costa, desde la eutrofización provocada por las escorrentías de los ríos Amazonas, Orinoco, Magdalena y Congo que desembocan en el océano e introducen grandes cantidades de nutrientes como producto
de la deforestación o el uso excesivo de fertilizantes en la agricultura, así como por posibles cambios en la circulación de las corrientes superficiales marinas provocadas por el incremento en la temperatura superficial del océano, o bien por el efecto combinado de ambos procesos. Lo anterior ocasiona que las algas del género Sargassum, que antes se encontraban casi exclusivamente al norte del Atlántico en el Mar de los Sargazos, ahora encuentren condiciones idóneas para proliferar más al sur, formando lo que recientemente se ha denominado como el “Cinturón de Sargassum” que se extiende desde las costas del Oeste de África hasta el Mar Caribe y el Golfo de México.
En el Mar Caribe, se reporta la presencia de dos especies pelágicas, Sargassum natans y Sargassum fluitans, que en años recientes han generado impactos negativos en los ámbitos ambiental y socioeconómico. Desde las costas de Trinidad y Tobago, República Dominicana, Cuba, Colombia y las costas del Caribe Mexicano, entre 2011 y 2018 se han registrado afluencias masivas de sargazo que con el tiempo han ido en aumento. Únicamente
en las costas del Caribe Mexicano, los reportes de la Secretaría de Ecología y Medio Ambiente (SEMA) de Quintana Roo indican que la biomasa algal retirada de las playas ascendió a 528 mil toneladas durante 2018. Reportes más recientes calculan que la biomasa flotante que podría llegar a acumularse frente a las costas de América del Sur y potencialmente distribuirse por el Caribe ronda los 20 millones de toneladas métricas [3]. Entre los efectos adversos que genera el gran volumen de algas que recalan en la costa, destacan la erosión de playas, la disminución en la cobertura de comunidades de pastos marinos, la contaminación de playas debido a la descomposición in situ del material algal, la contaminación de mantos freáticos por lixiviados debido a malas prácticas relacionadas con los sitios de disposición final del alga, incluyendo afectaciones al sector turístico y las comunidades aledañas.
Cabe señalar que la biodegradación de las especies del género Sargassum, depende de la disolución y degradación del alginato, principal componente estructural de su pared celular, mientras que otros compuestos reactivos también afectan su degradación biológica. Sin lugar a dudas, la degradación biológica de las algas después de un evento de arribazón, puede provocar efectos adversos a la salud de los ecosistemas circundantes. En ambientes cercanos a la costa, e incluso en zonas más profundas, la tasa de degradación está determinada por factores como la accesibilidad microbiana, condiciones de temperatura y pH. Como producto de la degradación biológica de las algas pardas, se generan gases (H2S, CO2, CH4), sólidos volátiles (materia orgánica) y una alta demanda química de oxígeno (DQO). Adicionalmente, diferentes compuestos disueltos como el manitol, ácidos
grasos volátiles, alcoholes y polifenoles pueden ser liberados de sus tejidos. Las bacterias que se involucran en estos procesos generalmente usan los productos para mantener su propio metabolismo [4], mientras que algunos otros nutrientes o iones liberados pueden provocar eutrofización. De igual forma, el proceso aeróbico que convierte la materia orgánica (carbohidratos, proteínas y lípidos) en CO2 y H2O a través de la hidrólisis bacteriana, ocurre a expensas del consumo de O2 originando zonas anóxicas. Adicionalmente, el metano, que deriva de la descomposición (principalmente del manitol y del alginato) también puede resultar perjudicial para el entorno.
Sin embargo, los grandes volúmenes algales que arriban a las playas tienen un gran potencial para ser aprovechados con diferentes fines, como se hace con otras especies de algas marinas, tanto en el país como en todo el mundo [5]. Sin embargo, para plantear cualquier propuesta de aprovechamiento es indispensable conocer aspectos básicos de las arribazones (Figura 2), tales como: ¿De qué forma varía espaciotemporalmente el volumen de algas que arriban a la playa?, ¿cuáles son las especies que componen dichas arribazones y en qué proporción se encuentran?, ¿existen variaciones espaciotemporales en la composición de las arribazones?, ¿cómo se reproducen estos organismos y cuál es el origen de los eventos masivos?, ¿qué sabemos acerca de la fisiología de las especies presentes? Y finalmente, información crucial para su aprovechamiento: ¿Cuál es la composición bioquímica de estas especies y cómo varía espaciotemporalmente?
En el Caribe Mexicano, las arribazones masivas han generado gran interés de la
comunidad científica, poniendo de manifiesto la urgencia de abordar los aspectos antes mencionados. Como parte de los esfuerzos para estudiar integralmente las algas del género Sargassum que han causado eventos de acumulación masiva en México, el Laboratorio de Ficología Aplicada y Ficoquímica Marina del Cinvestav Unidad Mérida, lidera el proyecto “Valorización de la biomasa de arribazón del género Sargassum para su uso y aprovechamiento” (CONACyT PN2015-01575).
Como parte de los resultados preliminares, se ha logrado conocer que la abundancia y composición de las arribazones en las costas de Quintana Roo varía tanto espacial como estacionalmente. Nuestras observaciones sugieren que la cantidad de biomasa de arribazón, y la forma que se deposita en la playas, no sólo depende de procesos a gran escala (corrientes marinas y vientos) que movilizan estas mareas doradas, sino también de las condiciones morfodinámicas de las playas a escala local, y que están determinadas por características como la pendiente, el oleaje, el tipo de sedimento y la presencia de elementos como roqueríos naturales, escolleras, barreras arrecifales o estructuras artificiales para el control de la erosión, entre otros, generando condiciones que promueven o afectan dichas acumulaciones. Por otro lado, se ha determinado que las arribazones estudiadas durante 2018-2019 son multiespecíficas, formadas por componentes pelágicos y bentónicos que varían en función de la localidad y de estacionalidad. Las especies pelágicas Sargassum fluitans, S. natans y un morfo tipo previamente reportado como S. natans VIII (pendiente de confirmar su identidad por métodos moleculares), representan el componente mayoritario de las arri-

Hasta el 90%
Sargassum natans l
Sargassum natans VIII
En meno r propo rción
Macroalgas bentónicas



Sargassum natans VIII abundantemente en el verano)
Pastos marinos
(Estas especies crecen adheridas al sustrato y son más abundantes en invierno)
Sargassum fluitans
Sargassum natans I
Estas algas se originan en el Océano Atlántico y son arrastradas a las playas del Caribe por las corrientes marinas.
bazones, entre 80 y 100%, mientras que otras especies bentónicas (otras macroalgas y pastos marinos) se encuentran en menor proporción, por debajo del 20%. La variación en la composición de las arribazones sugiere que la diversidad encontrada depende de las comunidades bentónicas adyacentes a las playas, cuya biomasa se desprende y se mezcla con las especies pelágicas que provienen de las masas flotantes (mareas doradas). Cabe destacar que la variación en la composición específica de las arribazones es un factor importante para considerar en las propuestas de aprovechamiento y manejo, ya que la composición bioquímica puede ser altamente variable entre las distintas especies presentes, tales como algas rojas, algas verdes y pastos marinos. Adicionalmente, la presencia de pastos marinos, cuya descomposición
ocurre rápidamente en la playa, puede acelerar la descomposición del resto de las especies algales. Finalmente, se ha demostrado que existen diferencias en la composición bioquímica entre las especies de Sargassum, por lo que su abundancia relativa determinará la composición de la arribazones. Sin duda, otras preguntas quedan en el aire. Lo cierto es que entre más conozcamos este fenómeno y sus repercusiones globales, regionales y locales, su monitoreo, contención o manejo y su potencial aprovechamiento será mucho más eficiente.
Artículo publicado en línea el 10 de octubre de 2019.

1. Cabral JP (2005) A apanha de algas na Ilha da Ínsua (Caminha) nos séculos XVII-XIX. Singularidades e conflitos. Finisterra XL, 80, 5-22.
2. Parr AE (1939) Quantitative observations on the pelagic Sargassum vegetation of the western North Atlantic. Bulletin of the Bingham Oceanographic Collection 6, 1–94.

3. Wang M, Hu C, et al (2019) The great Atlantic Sargassum belt. Science 365, 6448, 83-87.
4. Forro J (1987) Microbial degradation of marine biomass. En: Bird KT, Benson PH (Eds) Seaweed Cultivation for Renewable Resources. Elsevier, Amsterdam, 305-325.
5. Vázquez-Delfín E, Freile-Pelegrín Y, et al (2019) Seaweed resources of Mexico: Current knowledge and future perspectives. Botanica Marina 62, 3, 275–289.

Instituto de Física, Benemérita
Universidad Autónoma de Puebla
Egresado del Departamento de Física
Aplicada, Unidad Mérida, Cinvestav.*
Cráteres lunares
En 1609, Galileo Galilei describe detalladamente en su obra Siderius Nuncius (Mensajero Sideral) las observaciones astronómicas que en los dos últimos meses había logrado con el telescopio que acababa de inventar. Hasta ese entonces, se creía que la luna y los cuerpos celestes eran esferas perfectas, lo cual encajaba con la visión religiosa dominante. De sus observaciones lunares, Galileo concluyó:
“…La luna no es lisa ni regular, ni tiene forma exactamente esférica, como ha opinado la turba de filósofos, lo mismo que de otros cuerpos celestes. Todo lo contrario. Es desigual, áspera, con cavidades, con elevaciones, tal cual la tierra en su superficie, que


Figura 1. a) Imagen de la Luna. Crédito: E. TrujilloGarcía. b) Cráteres dibujados por Galileo en el Siderius Nuncius, 1609.
documentada de depresiones circulares en la superficie lunar, las cuales ahora conocemos como “cráteres”.
tiene montes y cañadas, valles y depresiones. Y éstas son las razones que me da la observación para afirmarlo…”.
Las observaciones de Galileo quedaron plasmadas como la primera evidencia
La palabra cráter viene del griego Krater que significa “tazón para mezclar” y se acuñó debido a la similitud de las depresiones lunares con la forma de un tazón antiguo que se utilizaba para mezclar vino y agua.
*Felipe Pacheco se doctoró en el Cinvestav en 2011, logrando el premio Rosenblueth y la medalla Weizmann por su tesis. Posteriormente ganó la prestigiosa beca Belspo-Marie Curie para realizar una estancia posdoctoral en la Universidad de Liège, en Bélgica. En 2021 fue galardonado con el Premio de Investigación para científicos jóvenes de la Academia Mexicana de Ciencias. Ver nota en Conexión Cinvestav: Premian a egresado del Cinvestav que ha estudiado cráteres de impacto.
¿Cuál era el origen de dichas depresiones en la superficie lunar? Galileo no planteó ningún origen; suficientes problemas le causó el describir algo en contra del perfecto mundo sideral de la visión cristiana dominante. Así, tuvieron que pasar varias décadas antes de que Robert Hooke propusiera en 1665 dos mecanismos: erupciones de gas o impactos. A esto se le sumó la actividad volcánica basada en observaciones terrestres. Mientras que una erupción volcánica claramente generaría un cráter, en aquel entonces se consideraba al espacio exterior vacío y la hipótesis de impactos quedó olvidada.
Durante más de 200 años la hipótesis del origen volcánico de los cráteres lunares fue dominante. Destacados astrónomos intentaron rescatar la teoría de impacto a inicios del siglo XIX, como el astrónomo alemán Franz Von Paula Gruithuisen; no obstante, unos meses antes publicó que había observado vacas pastando en las praderas lunares y un templo en forma de estrella, lo que le ganó el descrédito de la comunidad astronómica. La hipótesis de impacto retomó nuevamente fuerza a inicios del siglo pasado, cuando Alfred Weneger realizó una revisión exhaustiva de las distintas hipótesis existentes, y notó que reconocidos vulcanólogos, como Johnston-Lavis, habían destacado importantes diferencias entre los cráteres terrestres producidos por erupciones volcánicas y los cráteres lunares, por lo que descartaban la hipótesis volcánica. Basado en esto, Weneger realizó impactos a escala de laboratorio en el Instituto de Física de Marburg durante dos años (1918-1919).
La morfología de los cráteres obtenida en sus experimentos reproducía aquellas observadas en la luna: cráteres simples, con picos centrales, terrazas, borde elevados, etcétera [1]. Resultados similares se habían observado del impacto de proyectiles en pruebas militares. Por


otro lado, estudios geológicos realizados desde 1866 del cráter Barringer (Meteor Crater) en Arizona, concluyeron que ese cráter había sido formado por un meteorito de acero de unos 200 metros de diámetro. Todo apuntaba a que, como el cráter de Arizona, los cráteres lunares habían sido formados por impactos de meteoritos. Trabajos posteriores de Erns Opic, Algernon Glifford, Ralph Baldwing apuntalaron la teoría de impacto, la cual no fue totalmente aceptada sino a finales de los 60 con la llegada del hombre a la luna.
Cráteres en el laboratorio
Obviamente, el proceso de formación de un cráter por impacto de meteorito no puede estudiarse de manera sistemática a escala natural. Por tal motivo, durante las últimas dos décadas se ha estudiado el proceso a escala de laboratorio. En un experimento típico, proyectiles esféricos, sólidos o granulares, se dejan caer desde varias alturas sobre una cama plana de material granular (arena seca o húmeda). Tras la colisión, el material es expulsado desde el punto de impacto formando una cortina uniforme de granos que se dispersa radialmente, mientras se crea una depresión en el suelo que toma la forma final del cráter. Tales experimentos han demostrado que la morfología de los cráteres resultantes es muy similar a las observada en los cráteres planetarios, lo cual depende de la energía de impacto, del tamaño del grano, del factor de empaquetamiento del medio, entre otros factores [2].
Respecto a las dimensiones del cráter, se ha encontrado que su diámetro, D, escala como una ley de potencias con la energía de impacto E, con un exponente próximo a 1/4. Dicha dependencia se ha probado válida para un rango de energía de 16 órdenes de magnitud, desde cráteres de unos cuántos centímetros de diámetro formados en una cama de arena, como en la que juegan los niños, hasta cráteres de varios kilómetros observados en las superficies de los planetas. Cuando la energía de impacto es lo suficientemente baja, la vaporización o fusión de la esfera o del material impactado no ocurre. Así, D dependerá de cuatro parámetros independientes: E, la energía perdida por la esfera durante el impacto; d, el diámetro de la esfera; ρ, la densidad del material impactado; y g, la aceleración de la gravedad en la superficie de la Tierra. Este listado de parámetros excluye explícitamente el módulo de resistencia a la fractura del material granular. Tal exclusión implica que el material granular no está consolidado y que los granos pueden separarse sin gasto de energía. Aplicando el Teorema Pi-Buckingham al conjunto de 5 parámetros (D, E, d, ρ, g) y tres dimensiones independientes (longitud, masa, tiempo), se tienen 5-3 = 2 grupos adimensionales que pueden obtenerse por inspección: D/d y E/ ρgd4. Entonces D/d= f(E/ ρgd4). Puesto que experimentos simples de impacto muestran que D ∝ E1/4, entonces D ∝(E/ ρg)1/4 independientemente del diámetro de la esfera. Conforme la energía de impacto aumenta, se reportan pequeñas desviaciones de dicha ley de potencias.
Resumiendo: 1) los cráteres de impacto formados a escala de laboratorio siguen las mismas leyes de escalamiento con la energía que los cráteres a escala planetaria, D ∝ E1/4. 2) El material es expulsado uniformemente dejando un cráter cuya morfología es similar a la de cráteres lunares. Sin embargo, había un misterio que no había podido ser explicado o reproducido a escala de laboratorio durante las décadas de investigación de estos procesos: los llamados sistemas de rayos.


Cuando se observa la Luna con un telescopio, como en la Figura 1, se pueden distinguir lineas delgadas saliendo del cráter Tycho. Al conjunto de líneas se le denomina sistemas de rayos, los cuales son eyecciones de material en forma de líneas radiales que salen del punto de impacto y que se extienden considerablemente más allá del diámetro del cráter. Estas eyecciones pueden o no observarse alrededor de un cráter a escala plane-
taria, pero no habían sido observadas a escala de laboratorio hasta muy recientemente [3,4]. Durante los últimos seis meses se ha logrado un avance importante en la comprensión del proceso que da origen a los sistemas de rayos. Experimentalmente se demostró por primera vez que existen dos condiciones bajo las cuales se producen sistemas de rayos: a) cuando un proyectil esférico impacta contra una superficie ondulada [3], o b) cuando un proyectil con curvaturas pronunciadas impacta contra una superficie plana [4]. Dichos experimentos tienen gran relevancia considerando que las superficies planetarias no son necesariamente planas y que los meteoritos no son esferas perfectas. Los sistemas de rayos son entonces producidos cuando el material es expulsado en dirección no-radial, ya sea debido a la topología de la superficie o la forma del proyectil, por lo que las eyecciones pueden converger en cierto punto y ser re-dirigidas en un solo rayo.
Nos enfocaremos aquí en los sistemas de rayos y cráteres producidos por proyectiles no esféricos, investigación que fue publicada en Physical Review Letters [4]. La figura 3 muestra el impacto de dos proyectiles, uno perfectamente esférico y otro con protuberancias. Nótese que el material expulsado por la esfera forma una cortina uniforme de material, mientras que el material expulsado por el proyectil con 12 protuberancias forma 12 rayos.
La figura 4a esquematiza un sistema de rayos producidos por el impacto de un proyectil con protuberancias. El diagrama indica cómo el material siempre es expulsado a la superficie del proyectil, por lo que la eyección que proviene de una protuberancia colisiona con el material expulsado por la esfera, y al converger, forman un rayo con una ligera
desviación respecto a la dirección radial, la cual puede estimarse considerando la conservación del momento lineal. Si dos protuberancias son muy cercanas entre sí, como en el diagrama de la Fig. 4b, dos rayos adyacentes pueden superponerse y generar un rayo de mayor tamaño, por ello, en el caso mostrado en la figura 3, el número de rayos coincide con el número de protuberancias.
El lector seguramente cuestionará que un meteorito real no es un proyectil con protuberancias, sino más bien un proyectil amorfo con curvaturas marcadas o con pequeñas depresiones. La figura 5, tomada de [4], muestra que un proyectil deforme es capaz de generar un cráter con dos rayos eyectados desde las curvaturas más pronunciadas de su superficie. Esto indica que los sistemas de rayos observados en la luna pudieron haber sido producidos por el impacto de un meteorito con concavidades marcadas, como por ejemplo un meteorito de acero.
Además, obsérvese en la Figura 5 que el cráter resultante tiene una forma circular independientemente de la forma del proyectil. Esto fue corroborado usando proyectiles con distinta geometría de sección transversal y variando la energía de impacto. El cráter final pierde toda la información respecto a la forma del meteorito que lo creó, debido a que la cavidad generada por el impacto se hace más profunda conforme la energía de impacto aumenta. Éste es un resultado de gran relevancia, puesto que explica por qué la mayoría de los cráteres observados en la naturaleza son circulares a pesar de que un meteorito es amorfo.



Las principales aportaciones de la investigación fueron las siguientes [4]:
1. Sistemas de rayos pueden producirse por el impacto de un proyectil no esférico que hace converger el material expulsado en una sola dirección, siendo una posible explicación a los enigmáticos sistemas de rayos observados en la Luna.
2. Los cráteres se hacen circulares independientemente de la forma del proyectil conforme la energía de impacto aumenta, lo cual puede explicar porque los cráteres parecen ser circulares aun cuando los meteoritos son de forma irregular.
3. El diámetro del cráter, D, sigue una dependencia con la energía, E, tipo ley de potencias: D∝E1/4, independientemente de la forma del proyectil (o meteorito).
Cráteres producidos por otros mecanismos
Además de los cráteres generados por impacto de meteoritos y erupciones volcánicas, existen cráteres producidos por otros mecanismos, como los cráteres por hundimiento o “maars”. Un maar es producido cuando agua subterránea entra en contacto con el magma y se evapora, el aumento de presión en la cavidad que contiene el gas es capaz de fracturar la capa de rocas; cuando el gas escapa, la superficie se colapsa generando la depresión. Los cráteres también pueden ser producidos de manera artificial mediante explosiones, como el cráter Sedan de 6.5 x 106 m3 creado mediante la explosión de una bomba nuclear de 104 kilotones de TNT en Nevada, el cuál es el cráter más grande creado por el ser humano.
Dichos procesos de formación de cráteres también han sido estudiados a escala de laboratorio por nuestro grupo, utilizando materiales granulares, por ejemplo, cráteres producidos mediante explosiones de pequeñas cantidades de pólvora negra en arena [5], colapso

Figura 7. Cráter y chorro granular generado por el colapso de una cavidad presurizada.
de cavidades presurizadas localizadas a distintas profundidades de un lecho granular [6] y cráteres generados por ablación láser [7]. En el caso de explosiones y ablación láser, el diámetro del cráter escala con la energía liberada como D ∝E1/3. Nótese el exponente 1/3 en vez de 1/4 encontrado para impactos.
El análisis mediante perfilometría láser de la geometría de cráteres a escala de laboratorio reveló que cráteres generados por distintos mecanismos tienen distinto perfil: los creados por impacto son parabólicos con borde elevado, los creados por explosiones tienden a ser más hiperbólicos o cónicos, y los creados por colapso de cavidades son depresiones más esféricas sin borde elevado. Así, el análisis de la geometría del cráter nos permite obtener ciertas pistas sobre el posible origen del mismo.
En resumen, el uso de materiales granulares para estudiar formación de cráteres ha sido un método de gran relevancia durante las últimas décadas. Además de dar explicación a los enigmáticos sistemas de rayos.
Artículo publicado en línea el 20 de mayo de 2019.

1. Weneger A (1921) Die Entstehung der Mondkrater, Sammlung Vieweg, Heft 55.
2. Pacheco-Vázquez F & Ruíz-Suárez JC (2011) Phys. Rev. Lett 109, 218001.
3. Sabuwala T et al (2018) Phys. Rev. Lett. 120, 264501.
4. Pacheco-Vázquez F (2019) Phys. Rev. Lett. 122, 164501.
5. Pacheco-Vázquez F et al (2017) Phys. Rev. E 96, 032904.
6. Loranca FE et al (2015) Phys. Rev. Lett 115, 028001
7. Marston JO & Pacheco-Vázquez F (2019) Phys. Rev. E 99 030901(R).


